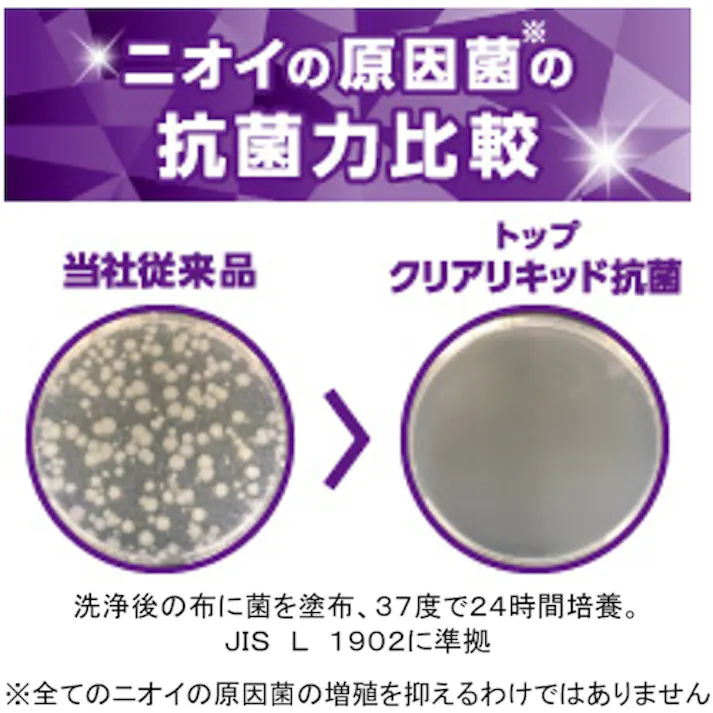
【CAINZ-DASH】ライオンハイジーン トップ クリアリキッド抗菌 4kg HETAG4【別送品】

【CAINZ-DASH】ライオンハイジーン トップ クリアリキッド抗菌 4kg HETAG4【別送品】
メーカー直送
※商品のデザインや仕様、原産国は予告なく変更となる場合がございます。ご指定はできませんのでご了承ください。
メーカー直送
最大注文数は0です
※価格は店舗や掲載場所で異なる場合があります。
基本送料のみ5,000円以上ご注文で基本送料無料
店舗での受取は送料無料
商品のお見積りご注文はこちら
「ご注文数が31個以上、または、ご注文金額5万円以上」でお買い上げご希望のお客様は、在庫・納期を確認いたします。こちらよりお問い合わせください。
※このフォームからのご注文は、各種ポイントキャンペーン対象外となります。
-
-
-
-
-
-
-
-
-
商品の詳細
商品コード
4903301288343
タイプ
液体
香り
さわやかなフレッシュフローラル
容量(g)
4000
容量(kg)
4
容量(L)
4
容量(ml)
4000
液性
弱アルカリ性
使用量目安
水30Lに対し25g
生産国
日本
重さ
4.100KG
-
-
-
-
-
-
-
-
-
-
-
-
-
-
-
-
-
-
商品説明
注意事項
配送地域・送料について
- 北海道、沖縄県、その他各都道府県の離島地域が配送先となる場合は、地域配送料(北海道:500円、沖縄県およびその他離島:1,700円)がかかります。これら以外の配送地域でも、一部商品において追加送料が発生する場合がございます。
- 離島の場合、配送日を指定しても指定日通り届かない場合がございます。
- 別送品は、北海道・沖縄・離島への配送は致しかねます。
- ご入力いただいたお届け先名、住所、電話番号をカインズ以外の出荷元に開示します。プライバシーポリシーの規定に則り厳重に取り扱います。
商品に関する注意事項・説明書
みんなが役に立ったレビュー
レビュー投稿する前に必ず約款をご確認ください。投稿した時点で約款に同意したものとみなします。
-
-
-
-
-
-
-
-
-
-
-
-
-
-
-
-
-
-